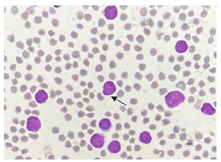

探讨急性未分化白血病(AUL)的临床特点、诊断与治疗方法,并进行相关文献复习。
选择2020年8月24日、2021年7月20日威海市立医院收治的2例AUL患者为研究对象。根据2例患者入院时间,将其依次编号为患者1、2。患者1~2均为男性,年龄分别为62、76岁。采用回顾性分析方法,收集其临床病例资料,包括临床特征及外周血常规、生化、凝血、骨髓细胞形态学、骨髓细胞免疫分型检查结果,诊断、治疗及预后。根据患者1~2临床症状及实验室检查结果,对其进行诊断及治疗。对患者1~2的随访分别截至2020年10月31日与2021年9月30日。本研究以"急性未分化白血病""系列不明急性白血病""急性髓细胞白血病""急性髓细胞白血病微分化型""acute undifferentiated leukemia""acute leukemia of ambiguous lineage""acute myeloid leukemia""acute myeloid leukemia with minimal differentiation""AUL""ALAL""AML"为中、英文关键词,检索中国知网数据库、万方数据知识服务平台和PubMed数据库中AUL相关文献,总结与本研究患者1~2相关的诊疗资料。文献检索时间为上述数据库建库至2022年8月30日。本研究获得威海市立医院伦理委员会审批(批准文号:2023042),并与患者签署临床研究知情同意书。
①患者1因"乏力2个月,发热2 d,伴胸闷、憋气1 d"入本院治疗,患者1既往有"2型糖尿病"病史;曾于当地医院就诊,疗效不佳,遂转入本院进一步治疗。患者2因"发现颈部右侧肿物10+ d"入本院治疗,同时右侧颈部疼痛,转颈吞咽时加重,伴发热,偶有胸闷、憋气,伴咳嗽;无其他疾病史和家族史。②入院后,患者1相关检查结果示,白细胞计数(WBC)为108.34×109/L,红细胞计数为2.86×1012/L,血红蛋白(Hb)值为92 g/L,血小板计数为7×109/L;B型钠尿肽前体、降钙素原、C反应蛋白水平进行性升高;骨髓细胞形态学检查结果示,原始细胞比例为97.00%;骨髓细胞免疫分型结果示,异常原始细胞占有核细胞比例为98.12%,表达CD34、CD38、CD13、CD123,部分表达CD9,弱表达人类白细胞抗原(HLA)-DR,除表达CD13外,不表达其他髓系、B系和T系相关和特异性抗原。患者2相关检查结果示,WBC为18.05×109/L,红细胞计数为4.88×1012/L,Hb值为141 g/L,血小板计数为49×109/L;C反应蛋白值升高;骨髓细胞形态学检查结果示,粒系原始细胞比例为84.00%;骨髓细胞免疫分型结果示,异常原始细胞占有核细胞比例为87.55%,表达CD7、CD38、CD99,小部分表达HLA-DR,部分表达CD34、CD33、CD123,小部分表达cCD3(阳性率为3.87%,细胞质抗体阳性率<10.00%),其余相关抗原均不表达。③患者1于2020年8月27日被诊断为AUL,遂于9月1日对其采取VDCP[长春新碱1.5 mg/(m2·d),d1~8+柔红霉素45 mg/(m2·d),d1~3+环磷酰胺750 mg/(m2·d),d1+泼尼松1 mg/(kg·d),d1~4、8~11]方案化疗,28 d为1个疗程。其接受2个疗程VDCP方案化疗后,由于年龄大且基础疾病较重,病情迅速复发恶化,患者家属放弃治疗。患者1出院后,血小板计数呈下降趋势,并于2020年10月10日合并严重感染死亡。患者2于2021年7月28日被诊断为AUL。由于患者2年龄大,遂于7月30日对其采取减低剂量VAP[长春新碱1.5 mg/(m2·d),d1~8+阿糖胞苷100 mg/(m2·d),d1~6+泼尼松1 mg/(kg·d),d1~7]方案化疗,28 d为1个疗程。其接受1个疗程减低剂量VAP方案化疗后,疗效较差,家属放弃治疗。患者2出院后,病情恶化严重,并于2021年9月10日大出血死亡。④根据文献检索策略,共纳入6篇报道8例AUL患者相关文献,加上本研究患者1~2共10例AUL患者。对这10例患者的研究结果显示,>60岁患者为4例,9例患者无合并症,4例患者初诊时伴淋巴结大,2例接受造血干细胞移植(HSCT)后缓解,1例接受DAVP(柔红霉素+阿糖胞苷+长春新碱+泼尼松)方案化疗后缓解,1例接受CAVD(环磷酰胺+阿糖胞苷+长春新碱+柔红霉素)方案化疗后缓解,1例接受DA(柔红霉素+阿糖胞苷)+依维替尼方案化疗后缓解,5例患者死亡。
AUL患者临床少见,该病以急性髓细胞白血病(AML)的临床表现为主,诊断主要依据骨髓细胞形态学与免疫分型检查,目前尚无统一治疗方案,患者预后较差。

版权归中华医学会所有。
未经授权,不得转载、摘编本刊文章,不得使用本刊的版式设计。
除非特别声明,本刊刊出的所有文章不代表中华医学会和本刊编委会的观点。
系列不明急性白血病(acute leukemia of ambiguous lineage,ALAL)是指没有明确单一系别分化的白血病,占急性白血病(acute leukemia,AL)的3%~5%。2016年世界卫生组织(World Health Organization,WHO)将ALAL划分为5种类型[1,2]:①急性未分化白血病(acute undifferentiated leukemia, AUL);②混合表型AL(mixed phenotype AL,MPAL)伴t(9;22)(q34.1;q11.2),BCR-ABL1融合基因;③MPAL伴t(v;11q23.3),KMT2A重排;④B系/髓系MPAL非特指型,⑤T系/髓系MPAL非特指型。其中,AUL是指原始细胞不表达系别特异性标志物,可表达髓系相关标志物CD13、CD33、CD117之一的一类临床罕见亚型[3],同时原始细胞无髓系细胞分化的形态学特点。该病在临床及生物学特征等方面尚无统一标准,诊断及治疗方面存在一定难度,患者总体治疗缓解率低、易复发,与其他类型白血病患者相比预后较差。近年来,随着免疫分型、染色体分析、基因检测等各项诊断技术的发展,相关研究者对AUL的认知也不断提高。本研究总结本院2例AUL患者的诊治经过,并复习相关文献,以期提高临床医师对AUL的认识。现将研究结果报道如下。
分别选择2020年8月24日、2022年7月20日,威海市立医院收治的2例AUL患者为研究对象。2例患者均为男性,年龄分别为62、76岁。本研究获得威海市立医院伦理委员会审批(批准文号:2023042),并与2例患者签署临床研究知情同意书。
本研究2例患者的AUL诊断参照《2016年版造血与淋巴组织肿瘤WHO分类》(WHO classification of tumors of hematopoietic and lymphoid tissues,2016)[1]。根据患者的血常规、外周血和骨髓细胞形态学、免疫分型,以及分子生物学等检查结果,对其进行诊断。
对2例患者进行的相关检查包括血常规、生化、凝血功能,血清免疫球蛋白(immunoglobulin,Ig),骨髓细胞形态学和免疫分型检查。分子生物学及细胞遗传学检查包括AL相关融合基因、基因突变筛查,染色体核型分析等。
目前AUL无标准治疗方案。根据《血液病诊疗规范(2014年第1版)》[4]对患者进行治疗,具体为①对于成年AUL患者,可选择急性髓细胞白血病(acute myeloid leukemia,AML)或者急性淋巴细胞白血病(acute lymphoblastic leukemia,ALL)方案化疗;②对于无法耐受积极化疗者,可以考虑使用去甲基化药物、低剂量阿糖胞苷或者长春新碱和类固醇进行低剂量化疗方案。
本研究患者1随访截至2020年10月31日,患者2随访截至2021年9月30日。随访期间每1~2周门诊复诊1次,以及不定期门诊复诊或者电话随访。随访内容包括患者临床症状、血常规检查结果等。
本研究文献检索策略为以"急性未分化白血病" "系列不明急性白血病" "急性髓细胞白血病" "急性髓细胞白血病微分化型" "acute undifferentiated leukemia" "acute leukemia of ambiguous lineage" "acute myeloid leukemia" "acute myeloid leukemia with minimal differentiation" "AUL" "ALAL" "AML"为中、英文关键词,分别在中国知网数据库、万方数据知识服务平台和PubMed数据库中,检索AUL相关文献,总结与本研究AUL患者相关的诊疗资料。文献检索时间为上述数据库建库至2022年8月30日。本研究文献纳入标准:①文献为病例报道,②文献所报道病例的一般临床资料、治疗方案及预后资料完整;排除标准:①不能下载全文,②所报道病例合并其他血液病。
采取回顾性分析法,对本研究2例AUL患者的临床病例资料进行分析。同时,对根据本研究设定的检索策略获得的AUL相关文献进行复习,并对AUL患者的临床特征及诊疗进行分析、总结。
患者1,男性,62岁,2020年8月24日因"乏力2个月,发热2 d,伴胸闷、憋气1 d"入院。既往有"2型糖尿病"病史。曾于当地医院就诊,疗效不佳,遂转入本院进一步治疗。体格检查:神志清,精神不振,急性面容,喘憋貌;全身皮肤散在瘀斑;双肺呼吸音粗,可闻及湿性啰音;心律齐,未闻及病理性杂音;腹软,无压痛及反跳痛,肝脾肋下未触及;双下肢水肿,左足为著。患者否认其他疾病史及家族史。
患者2,男性,76岁,2021年7月20日因"发现颈部右侧肿物10+ d"入院,同时右侧颈部疼痛,转颈吞咽时加重,伴发热,偶有胸闷、憋气,伴咳嗽。患者为求系统治疗于本院就诊。体格检查:颈软,无颈静脉曲张及颈动脉异常搏动,气管居中,甲状腺不大,未触及明显结节,右侧颈部颌下区可触及约2.0 cm×2.0 cm质韧肿物,压痛明显,边界欠清,双侧胸锁乳突肌后缘、下颌下腺区、可触及多发大小不等的质韧肿物,边界欠清,无压痛。患者否认其他疾病史及家族史。
入院后,患者1实验室检查结果如下。血常规检查结果示,白细胞计数(white blood cell count,WBC)为108.34×109/L,红细胞计数为2.86×1012/L,血红蛋白(hemoglobin,Hb)值为92 g/L,血小板计数为7×109/L,C反应蛋白值为201.28 mg/L;外周血生化检查结果示,葡萄糖值为18.52 mmol/L,尿素值为14.95mmol/L,血清总钙值为1.72 mmol/L,肌酐值为123.3 μmol/L,乳酸脱氢酶值为358.3 U/L,α-羟丁酸脱氢酶值为267 U/L,B型钠尿肽前体值为1 172 pg/mL,降钙素原值为100 ng/mL;凝血功能结果示,凝血酶原时间为20.6 s,活化部分凝血活酶时间为45.9 s,凝血酶时间为14.6 s,纤维蛋白原值为6.3 g/L,D-二聚体值为29.12 mg/L;IgG值为5.41 g/L,IgM值为0.29 g/L,补体C3值为0.34 g/L。骨髓细胞形态学检查结果示,骨髓增生活跃,原始细胞占有核细胞的比例为97.00%,该类细胞大小不等,形态规则;细胞核类圆形或者不规则,可见凹陷裂痕,染色质颗粒状多聚集,多数细胞可见核仁;细胞质量少(图1)。粒、红两系细胞各阶段少见或者缺如。红细胞大小不等,破坏细胞多见。未见巨核细胞,血小板少见,未见其他异常细胞及寄生虫。骨髓细胞免疫分型结果示,可见异常原始细胞,占有核细胞的比例为98.12%,表达CD34、CD38、CD13、CD123,部分表达CD9,弱表达人类白细胞抗原(human leukocyte antigen,HLA)-DR,除表达CD13外,不表达其他髓系、B系和T系相关和特异性抗原(图2)。二代测序及细胞遗传学检查结果示,AL相关43种融合基因突变筛查呈阴性;AL相关51个基因突变筛查未见异常;染色体核型正常。


注:箭头示异常原始细胞。AUL为急性未分化白血病


注:AUL为急性未分化白血病,HLA为人类白细胞相关抗原,MPO为髓过氧化物酶
患者2,2021年7月20日入院后实验室检查结果如下。血常规检查结果示,WBC为18.05×109/L,红细胞计数为4.88×1012/L,Hb值为141 g/L,血小板计数为49×109/L,C反应蛋白值为83.68 mg/L;外周血生化检查结果示,丙氨酸转氨酶值为52.4 U/L,谷氨酰转肽酶值为289.2 U/L,天冬氨酸转氨酶值为65.4 U/L,碱性磷酸酶值为167.2 U/L,乳酸脱氢酶值为959 U/L;凝血功能结果示,纤维蛋白原值为4.46 g/L,抗凝血酶Ⅲ值为70.8%,D-二聚体值为2.9 mg/L;IgM值为2.39 g/L,血清β2微球蛋白值为4.72 mg/L。骨髓细胞形态学检查结果示,骨髓增生活跃,异常原始细胞占有核细胞比例为84.00%,该类细胞体积大小不等,部分形态不规则;细胞核类圆或者不规则,染色质颗粒状,部分可见核仁;细胞质量较少,着灰蓝色(图3)。幼稚粒细胞及成熟粒细胞少见。早期阶段红系细胞未见,偶见晚幼红细胞。红细胞形态未见明显异常。淋巴细胞数目无明显增减,形态大致正常。浆细胞可见,比例、形态均大致正常。全片未见巨核细胞。血小板少见。未见其他异常细胞及寄生虫。骨髓免疫分型结果示,异常原始细胞占有核细胞的比例为87.55%,表达CD7、CD38、CD99,小部分表达HLA-DR,部分表达CD34、CD33、CD123,小部分表达cCD3(阳性率为3.87%,细胞质抗体阳性率<10.00%),其余相关抗原均不表达(图4)。二代测序及细胞遗传学检查结果示AL相关43种融合基因突变筛查呈阴性;染色体核型正常。


注:箭头示异常原始细胞。AUL为急性未分化白血病


注:AUL为急性未分化白血病,HLA为人类白细胞相关抗原,MPO为髓过氧化物酶
患者1于2020年8月27日被诊断为AUL,并于9月1日起接受VDCP(长春新碱+柔红霉素+环磷酰胺+泼尼松)方案化疗,具体方案为长春新碱1.5 mg/(m2·d),d1~8;柔红霉素45 mg/(m2·d),d1~3;环磷酰胺750 mg/(m2·d),d1;泼尼松1 mg/(kg·d),d1~4、8~11,28 d为1个疗程,完成2个疗程VDCP方案化疗。9月8日复查血常规检查结果示,WBC为1.26×109/L,红细胞计数为2.07×1012/L,Hb值为63 g/L,血小板计数为10×109/L。患者Hb值和血小板计数较低,符合输血指征,遂于9月9日输注去白细胞单采血小板1.0 U,以及去白细胞悬浮红细胞2.0 U。输血过程顺利,输血后无不良反应。由于患者1年龄大且基础疾病较重,病情迅速复发恶化,患者家属放弃治疗,并于2020年9月10日出院。
患者2于2021年7月28日被诊断为AUL,并7月30日起接受1个疗程减低剂量VAP(长春新碱+阿糖胞苷+泼尼松)方案化疗,具体方案为长春新碱1.5 mg/(m2·d),d1~8;阿糖胞苷100 mg/(m2·d),d1~6;泼尼松1 mg/(kg·d),d1~7; 28 d为1个疗程。8月5日复查血常规结果示,WBC为2.08×109/L,红细胞计数为3.02×1012/L,Hb值为87 g/L,血小板计数为4×109/L。患者血小板极低,有出血风险,遂于8月6日输注A型Rh+去白细胞悬浮红细胞2.0 U,以及去白单采血小板12.0 U,输血过程顺利,输血后无不良反应。由于患者2年龄较大,仅能采用低剂量化疗药物,效果较差,家属放弃治疗,并于2021年8月17日出院。
出院后,患者1血小板计数呈下降趋势。2020年9月20日复查血常规检查结果示,WBC为9.84×109/L,红细胞计数为2.72×1012/L,Hb值为86 g/L,血小板计数为18×109/L;2020年9月30日复查血常规检查结果示,WBC为1.79×109/L,红细胞计数为2.71×1012/L,Hb值为86 g/L,血小板计数为2×109/L。2020年10月10日,患者由于合并严重感染而死亡。
出院后,患者2于2021年8月15日复查血常规检查结果示,WBC为12.19×109/L,红细胞计数为4.83×1012/L,Hb值为139 g/L,血小板计数为30×109/L;2021年8月22日复查血常规检查结果示,WBC为3.97×109/L,红细胞计数为3.61×1012/L,Hb值为104 g/L,血小板计数为5×109/L;2021年8月30日复查血常规检查结果示,WBC为1.4×109/L,红细胞计数为2.71×1012/L,Hb值为79 g/L,血小板计数为2×109/L。2021年9月10日,患者由于大出血而死亡。
按照本研究设定的文献检索策略,共检索出6篇AUL相关文献,报道8例AUL患者,加上本研究2例,共10例患者的临床特征资料,见表1。10例患者中,8例为男性,2例为女性,>60岁患者为4例,9例患者无合并症,4例患者初诊时伴淋巴结大,2例接受造血干细胞移植(hematopoietic stem cell transplantation,HSCT)后缓解,1例接受DAVP(柔红霉素+阿糖胞苷+长春新碱+泼尼松)方案化疗后缓解,1例接受CAVD(环磷酰胺+阿糖胞苷+长春新碱+柔红霉素)方案化疗后缓解,1例接受DA(柔红霉素+阿糖胞苷)+依维替尼方案化疗后缓解,5例患者死亡。

相关文献报道的10例AUL患者的临床特征
相关文献报道的10例AUL患者的临床特征
| 文献(第一作者,文献发表年) | 性别 | 年龄(岁) | 合并症 | 淋巴结大 | 治疗方案 | 预后 |
|---|---|---|---|---|---|---|
| 张前鹏[5],2016 | 男 | 36 | 无 | 是 | DAVP方案 | 缓解 |
| 张前鹏[5],2016 | 男 | 65 | 无 | 是 | IDAL方案 | 死亡 |
| 王柔嘉[6],2020 | 男 | 31 | 无 | 是 | DAVP方案 | 死亡 |
| Qasrawi[7],2020 | 男 | 62 | 无 | 是 | CAVD方案 | 缓解 |
| Patel[8],2020 | 女 | 39 | 无 | - | DA方案+依维替尼 | 缓解 |
| 刘文俐[9],2021 | 男 | 28 | 无 | - | DA方案 | 死亡 |
| Caldwell [10],2021 | 女 | 12 | 无 | - | HSCT | 缓解 |
| Caldwell [10],2021 | 男 | 19 | 无 | - | HSCT | 缓解 |
| 本研究患者1 | 男 | 62 | 2型糖尿病 | 无 | VDCP方案 | 死亡 |
| 本研究患者2 | 男 | 76 | 无 | 无 | VAP方案 | 死亡 |
注:"-"示原文献未提及相关内容。AUL为急性未分化白血病,DAVP为柔红霉素+阿糖胞苷+长春新碱+泼尼松,IDAL为伊马替尼+柔红霉素+阿糖胞苷+左旋门冬酰胺酶,CAVD为环磷酰胺+阿糖胞苷+长春新碱+柔红霉素,DA为柔红霉素+阿糖胞苷,HSCT为造血干细胞移植,VDCP为长春新碱+柔红霉素+环磷酰胺+泼尼松,VAP为长春新碱+阿糖胞苷+泼尼松
近年来,AL的诊断和治疗取得了重大进展。AL不再是一种病死率极高的疾病,AL患者可以接受治疗,而且可以治愈。随着各项诊断技术的不断发展,多种不同类型的AL已被识别。AUL是一种罕见的、无任何谱系分化标志物的AL。早期流行病学研究发现,AUL年发病率为1.6/106[11]。最近相关研究调查结果显示,AUL的年发病率为1.34/106[12]。AUL年发病率下降的原因可能是更有效的诊断方法,能够将AL患者精确划分为不同亚型。与AML(65岁)和ALL(12岁)患者相比,AUL患者的中位发病年龄最高(74岁),71%的AUL患者年龄≥60岁。本研究中患者1年龄为62岁,患者2为76岁。AUL临床表现与其他AL相似,可出现发热、贫血、出血。实验室检查结果可见WBC升高,血小板计数减少。本研究2例患者的临床特征与此相符,其中患者1的WBC急剧升高(>100×109/L)。患者2的初发临床表现为颈部右侧颌下区大小约为2.0 cm×2.0 cm质韧肿物,压痛明显,具有该特征AUL病例较罕见。张前鹏等[5]及王柔嘉等[6]报道,AUL患者可有浅表淋巴结大。此外,2例患者的炎症标志物C反应蛋白水平均较高。
光学显微镜下,AUL细胞无髓系细胞分化特征(细胞质无颗粒),体积中等,细胞核圆形或者类圆形,核仁明显;细胞质量少,无Auer小体。本研究2例患者的骨髓细胞形态学均与上述特点相符。由于AUL患者骨髓中原始细胞无髓系细胞分化形态特点,造成骨髓细胞形态学诊断存在一定困难,骨髓细胞免疫分型成为诊断AUL的一种有效方法。AUL不表达CD19、cCD79a、CD22等B系细胞标志物,不表达cCD3,髓过氧化物酶(myeloperoxidase,MPO)等T系及髓系细胞标志物[13],同时也不表达,其他细胞系标志物,仅表达原始细胞标志物CD34,CD38,末端脱氧核苷酸转移酶(terminal deoxynucleotide transferase,TdT)和HLA-DR。本研究中患者2有少部分骨髓细胞表达cCD3,不符合MPAL的诊断标准,但是不能排除疾病向T系肿瘤进展的可能。AUL在临床鉴别诊断中,难点在于与微分化AML[AML法国-美国-英国(French-American-British,FAB)分型AML-M0型]的区分,二者均无谱系分化,MPO及酯酶呈阴性;但二者重要鉴别点在于AUL患者通常不表达或仅表达1种谱系细胞表面标志物(CD13、CD33、CD117)[14,15],而AML-M0患者至少表达2种。Weinberg等[16]将24例AUL与30例AML-M0患者进行研究发现,二者的CD34表达无明显差别,AUL患者TdT表达较多,AML-M0患者CD123表达较多;在10例复发AUL患者中,9例患者的骨髓细胞免疫表型与复发前相同,而1例患者出现了复发前未发现的CD13和CD33新表达;24例AUL患者中13例缺乏CD13或者CD33表达,6例缺乏所有髓系细胞标志物(CD117、CD13、CD33)表达,所有患者均不表达淋系细胞标志物,11例表达CD117。Heesch等[17]针对16例AUL患者的研究发现,大多数患者伴CD34、TdT和HLA-DR的表达,谱系特异性标志物未表达。Kurosawa等[3]对12例AUL患者的研究发现,60%(7/12)患者存在CD13表达。Heesch等[17]研究发现,80%的AUL患者存在异常核型,这表明AUL患者中染色体异常的发生率较高。Qasrawi等[7]报道,70%(7/9)的AML患者核型正常,并且AUL年轻患者的遗传复杂性较低。Weinberg等[16]研究发现,AUL患者发生异常核型的比例为41%(10/24)。本研究2例AUL患者中,原始细胞均表达CD34、CD123,不表达CD117,均为正常染色体核型,同时与白血病相关的融合基因及基因突变筛查均为阴性,与上述研究报道略有不同。由于AUL病例少见,相关研究数据也有限,目前相关研究之间的异质性较大。
由于AUL病例少见且缺乏明确的危险度分层系统,目前并没有统一、明确的治疗方案。笔者建议可以针对不同人群,实施个体化治疗方案。青年患者可采用适用于ALL患者的多药化疗方案。对于成年患者,AML或者ALL方案均可接受;不能耐受化疗的患者,可考虑使用低甲基化药物、长春新碱等进行低剂量化疗[18];若患者有匹配的供者,可考虑进行allo-HSCT。AUL患者治疗方案的决策需要考虑到细胞遗传学、分子诊断、化疗反应及微小残留病等多方面因素[19]。传统的AML或者ALL化疗方案,很难使AUL患者达完全缓解,且复发率高。Heesch等[17]报道,10例AUL患者中,5例采用AML方案,4例采用ALL方案,1例采用混合方案治疗后,3年总体生存(overall survival,OS)率为44%。刘文俐和黎承平[9]报道,1例AUL患者首先采用AML化疗方案[DA(柔红霉素+阿糖胞苷)方案],染色体及融合基因结果示BCR/ABL呈阳性后,联合应用伊马替尼,缓解后开始采用ALL方案[CAM(环磷酰胺+阿糖胞苷+甲氨蝶呤)方案]巩固化疗,但是患者仍迅速复发。随着对白血病研究的不断深入,新的治疗药物,如Fms样酪氨酸激酶(Fms-like tyrosine kinase,FLT)3抑制剂,B细胞淋巴瘤/白血病(B cell lymphoma/leukemia,BCL)-2抑制剂,异柠檬酸脱氢酶(isocitrate dehydrogenase,IDH)抑制剂,去甲基化药物等已应用于临床AUL患者治疗,且有显著疗效[20]。最近,文献报道,1例伴IDH1突变AUL患者对化疗无反应,但是对IDH-1靶向治疗药物ivosidenib较敏感[8]。维奈克拉为BCL-2抑制剂,其对于FAB分型AML-M0及-M1患者较敏感。Caldwell等[10]研究报道,2例复发AUL患者经维奈克拉治疗后效果显著。其中,1例患者入院时病情较严重(急性面容、喘憋貌),白血病诊断期间出现重症肺炎及Ⅰ型呼吸衰竭,经积极无创通气、抗感染及营养支持等综合治疗,待病情稳定后采用ALL方案化疗,但是由于该患者的基础病较严重且年龄大(62岁),病情迅速复发、恶化。另一例患者年龄亦较大(76岁),且化疗风险高、预后较差。遂先应用激素7 d,减轻肿瘤负荷,同时应用阿扎胞苷进行治疗,但是患者发生消化道不良反应,随后加用BCL-2抑制剂维奈克拉治疗,疗效较差。年龄是影响AUL患者OS期的重要因素,AUL老年患者预后较年轻患者差。Qasrawi等[7]分析2000—2016年监测、流行病学和最终结果(Surveillance,Epidemiology,and End Results,SEER)数据库登记的1 444例AUL患者生存情况,结果显示,全部AUL患者的中位OS期为2个月。仅有35%(505/1 444)的AUL患者接受化疗,而94%(20 101/21 385)的ALL和71%(26 818/37 772)的AML患者接受化疗。在接受化疗的AUL患者中,中位OS期为12个月,而未接受化疗者的中位OS期为1个月(或者状态未知)。AUL成年患者的中位OS期为9个月,而ALL患者为27个月,AML患者为13个月。AUL患儿的中位OS期优于AML患儿,与ALL患儿相近。Weinberg等[16]研究结果显示,24例AUL和30例AML-M0患者的OS期分别为15、18个月,二者比较,差异无统计学意义(P>0.05)。
AUL总体治疗缓解率低,临床罕见,可供研究的病例少,可建立罕见病例数据库,方便临床数据研究汇总。近年来,随着多参数流式细胞术、基因检测和染色体分析等方面检查技术的不断完善,临床医师对AUL的认识和诊疗水平有所提高,有望进一步研究更有效、合理的治疗方法,从而改善AUL患者预后。
所有作者声明无利益冲突